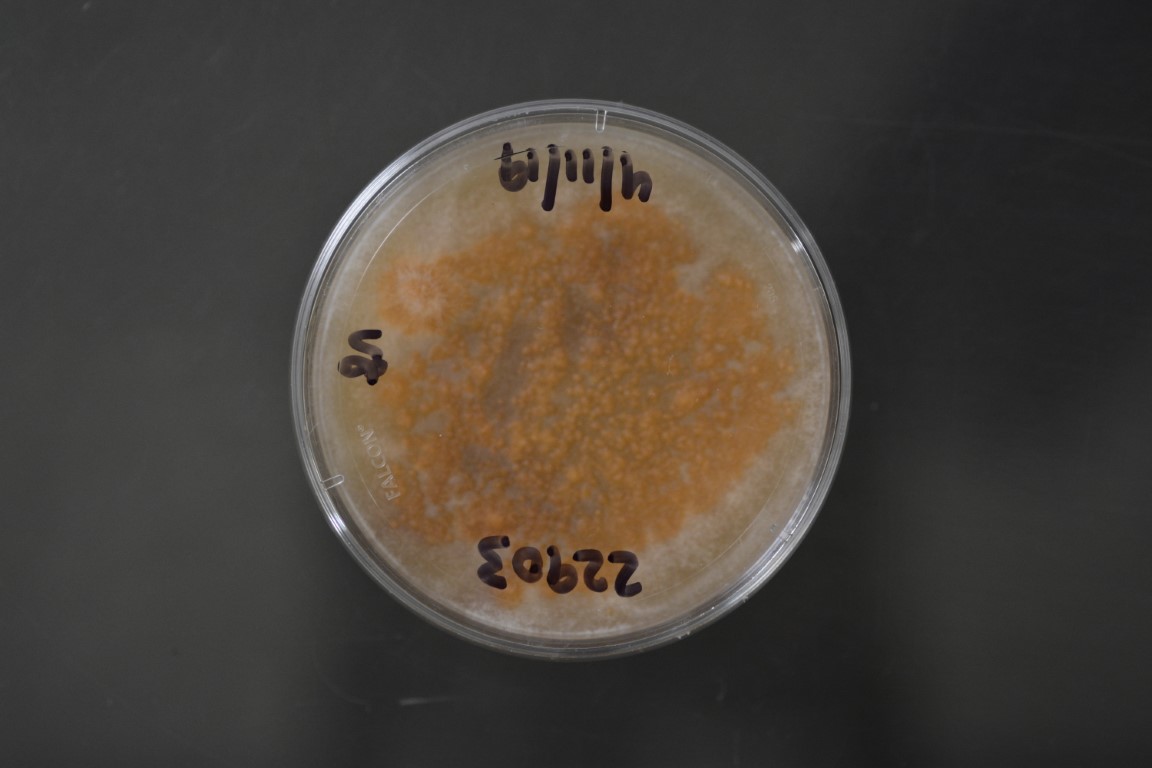

Fusarium commune
NRRL 22903
Accession numbers in other collections:BCRI 3139=DAOM 225157=IMI 375363
Source:P.Axelrood
Isolated from(substrate):Douglas fir germling
Substrate location:Oregon,USA
Genetic info:(Skovgaard K et al.Mycologia 95:630-636.2003)
Growth media:Half-strength V8 Juice Agar(1/2 V8)(number 40)
Optimum growth temperature:25C
Strain images:
NRRL_22903_17.JPG

Comments:Isolated and identified by P.Hamm in 1987;Ref:Mycologia,90(3),1998,465-493;Gams W et al.Mycologia 91:263-268.1999
This strain is a regulated plant pathogen.An APHIS PPQ 526 permit is required for distribution in the United States.For international requests,an importation permit or an official letter from the appropriate government agency declaring that a permit is not required must be provided in advance of shipment.
NRRL22903